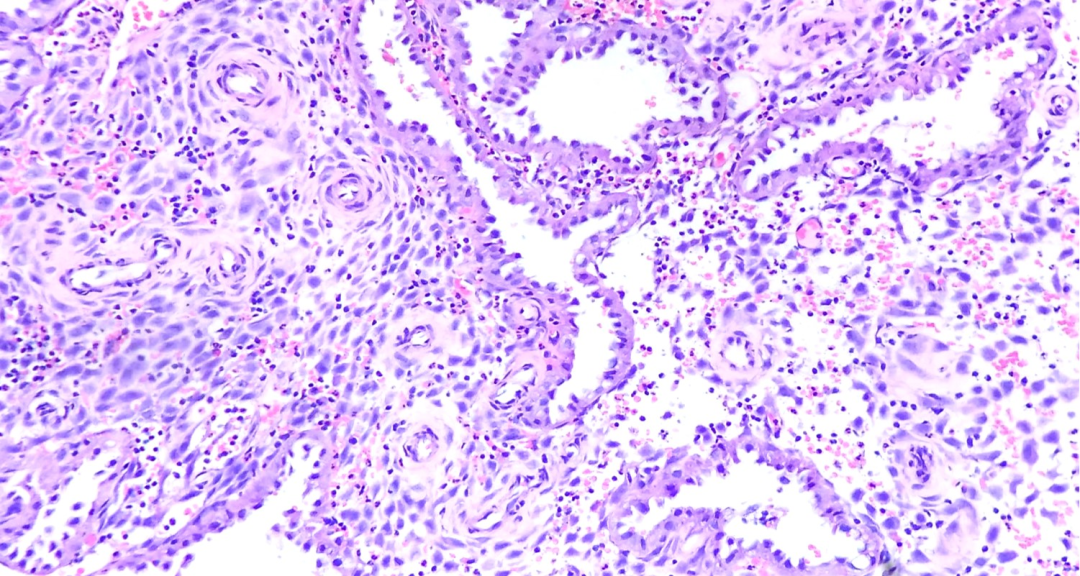
图片

子宫内膜:


·增生期

非分支、非出芽、形状类似的腺体均匀地分布在整个间质中、间质细胞为单形性未分化细胞、胞浆稀少、细胞边界不清、血供来自发育均一的分枝状薄壁血管,典型者腺体-间质比例为1:1。增生早期,腺体呈管状,管腔狭窄,当增生继续时,腺体盘绕逐渐增加,腺腔增大。
进一步发展的标志是:假复层、核分裂活跃、细长的伴有致密染色质的上皮细胞以及核分裂活跃的间质细胞。血管不明显,类似于毛细血管
正常增生期的形态结构还可能见于无排卵周期并与外源性雌激素治疗有关
·间期
实际上是晚期增生期子宫内膜,其腺体盘绕,半数以下的上皮细胞具有数量不同、非均一的核下空泡。
不能保证已经排卵,排卵后1-2天也可能有这种表现
·分泌期
分泌早期 排卵后2-5天



腺体盘绕,腺上皮细胞类似于增生期子宫内膜,但半数以上的腺上皮细胞含有相对大的胞浆空泡(标志)。腺体位于非前蜕膜的间质中。这种形态的精确日期取决于胞浆空泡的位置(核下或核上)和核分裂象的数目。
分泌中期 排卵后6-8天

分泌中-晚期
完全盘绕的分泌性腺体,内衬圆形细胞,常呈空泡状的细胞核。这种细胞的胞浆不含大的胞浆空泡,但腺腔内可能出现分泌物。间质尚未开始前蜕膜化。缺乏广泛的空泡和前蜕膜(标志)
分泌晚期 排卵后9-14天
分泌中-晚期


低倍镜下螺旋动脉显著,这不仅是由于螺旋动脉管壁增厚,更主要的是由于其周围有前蜕膜间质细胞套。前蜕膜细胞最初位于螺旋动脉的周围,然后扩大并在浅表子宫内膜间质中形成前蜕膜细胞岛,晚期分泌期开始的标志。在晚期分期的终末,这些蜕膜岛逐渐融合,月经即将来临时被间质出血所分隔。伴随着子宫内膜间质进行性的前蜕膜化,间质颗粒细胞数目增加。
·月经期
充分发育的分泌期子宫内膜的退变碎片。腺体扩张,内衬扁平细胞,常常伴有破损的边缘(分泌衰竭),间质完全前蜕膜化。在某些腺体的核下区域可见核破裂碎片(凋亡)、细胞边缘破损、上皮细胞核固缩,血管内出现纤维素性血栓,有时在间质内。(辨认子宫内膜退变,纤维素性血栓是一个非常有用的特征。)当月经期继续进行时,腺体破裂成条带,间质崩溃,上皮细胞失去黏附。
对月经出血与异常子宫内膜组织脱落进行鉴别,例如增生期子宫内膜过早脱落、子宫内膜增生脱落以及癌退变碎片的脱落。
附1:子宫内膜周期性变化示意图

附2:子宫内膜按日诊断路线图

附3:月经周期每日形态变化

附4:子宫壁切面

参考文献:
1.回允中(主译).《斯滕伯格诊断外科病理学》,2017年第6版,北京大学医学出版社
2.回允中(主译).《罗塞和阿克曼外科病理学》,2021年第 11 版,北京大学医学出版社